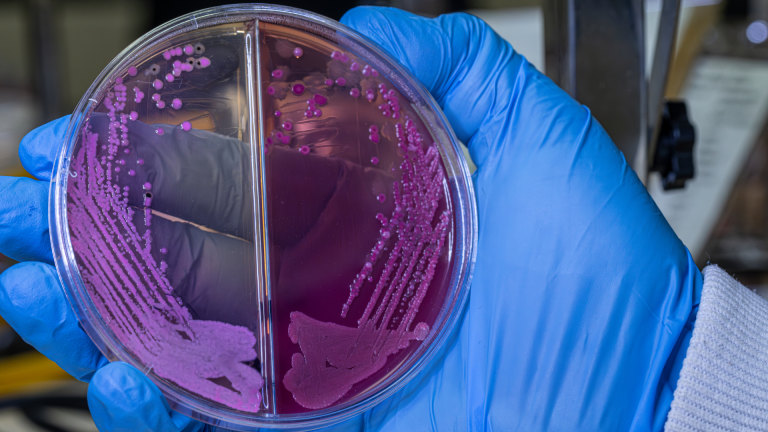
Gaita Kültürü

Gaita Kültürü
Gaita kültürü, ishal ve bağırsak enfeksiyonlarına yol açan Salmonella, Shigella, Campylobacter ve benzeri bakterilerin dışkı örneğinde üretilerek saptanmasını sağlayan mikrobiyolojik bir tanı yöntemidir. Uygulama, özellikle bakteriyel kaynaklı ishal şüphesi bulunan hastalarda enfeksiyon etkeninin doğrudan belirlenmesini amaçlar.
Gaita kültüründe alınan dışkı örneği, özel besiyerlerine ekilerek kontrollü koşullarda inkübe edilir. Üreyen mikroorganizmalar tanımlanır ve klinik bulgularla birlikte değerlendirilir. Bu yöntem viral veya paraziter nedenleri göstermez; bu nedenle her ishal vakasında değil, ateş, kanlı ishal, uzun süren ishal veya gıda zehirlenmesi şüphesinde tercih edilir.
Test için hemen arayın, size yardımcı olalım.
Gaita Kültürü Hangi Durumlarda İstenir?
Gaita kültürü, özellikle bakteriyel kaynaklı ishal ve bağırsak enfeksiyonu şüphesi bulunan durumlarda istenir. Klinik tabloya göre her ishal vakasında değil; belirli alarm bulguları varlığında tanı koydurucu değer taşır.
Gaita kültürü, kanlı ishal, yüksek ateşle seyreden ishal, uzun süren veya ağır ishal, gıda zehirlenmesi şüphesi ve yurt dışı seyahat sonrası gelişen ishal gibi durumlarda tercih edilir. Ayrıca bağışıklık sistemi baskılanmış bireylerde ve antibiyotik tedavisine yanıt vermeyen vakalarda etkenin netleştirilmesi için kullanılır. Bu yaklaşım, gereksiz test yapılmasını önlerken doğru tedavinin seçilmesini sağlar.
Gaita Kültürü Hangi Bakterileri Gösterir?
Gaita kültürü, bağırsak enfeksiyonlarına neden olan belirli patojen bakterilerin saptanmasını sağlar ve özellikle bakteriyel gastroenteritlerin ayırıcı tanısında kullanılır. Uygulama, dışkı örneğinde üreyebilen bakterilere odaklanır ve her mikroorganizmayı kapsamaz.
Gaita kültüründe en sık araştırılan etkenler Salmonella, Shigella ve Campylobacter türleridir. Klinik duruma ve laboratuvarın çalışma protokolüne bağlı olarak bazı patojen Escherichia coli türleri de değerlendirilebilir. Buna karşılık virüsler, parazitler ve toksin aracılı ishaller bu yöntemle saptanamaz. Bu nedenle gaita kültürü, gerektiğinde parazit incelemesi veya moleküler testlerle birlikte planlanarak tanısal doğruluk artırılır.

Gaita Kültürü Nasıl Yapılır?
Gaita kültürü, hastadan alınan dışkı örneğinin laboratuvarda özel besiyerlerine ekilmesi ve belirli bir süre kontrollü koşullarda inkübe edilmesiyle gerçekleştirilir. Amaç, dışkıda bulunan patojen bakterilerin çoğalmasını sağlayarak tanımlanabilir hâle getirmektir.
Uygulama sürecinde dışkı örneği, bakteri üremesini destekleyen ve ayırt edici özellik kazandıran besiyerlerine ekilir. İnkübasyon süresinin ardından üreyen koloniler mikroskobik ve biyokimyasal yöntemlerle değerlendirilir. Gerekli durumlarda antibiyotik duyarlılık çalışmaları da yapılabilir. Bu süreç, hızlı sonuç veren testlere kıyasla daha uzun sürse de etkenin doğrudan gösterilmesi açısından yüksek tanısal değer sağlar.
Gaita Kültürü İçin Örnek Nasıl Alınır?
Gaita kültürü için doğru sonuç elde edilmesinin en kritik aşaması, dışkı örneğinin uygun şekilde alınmasıdır. Yanlış veya kontamine alınan örnekler, bakterilerin üremesini engelleyerek hatalı sonuçlara yol açabilir.
Dışkı örneği, temiz ve kuru bir kaba alınmalı; idrar, su veya tuvalet kağıdı ile temas etmemelidir. Örnek, tercihen dışkının kanlı, mukuslu veya sulu kısmından seçilmelidir. Özel taşıma kabı kullanılıyorsa, örnek alındıktan sonra kap sıkıca kapatılmalı ve en kısa sürede laboratuvara ulaştırılmalıdır. Uygun koşullarda alınan örnek, gaita kültürünün tanısal değerini doğrudan artırır.
Gaita Kültürü Öncesi Nelere Dikkat Edilmelidir?
Gaita kültürü öncesinde dikkat edilmesi gereken en önemli nokta, test sonucunu etkileyebilecek ilaç ve uygulamaların zamanında değerlendirilmesidir. Özellikle antibiyotik kullanımı, dışkıdaki bakterilerin baskılanmasına yol açarak yanlış negatif sonuçlara neden olabilir.
Gaita kültürü planlanmadan önce son günlerde antibiyotik kullanımı, ishal kesici ilaçlar ve bağırsak florasını etkileyen tedaviler mutlaka laboratuvarla paylaşılmalıdır. Antibiyotik tedavisi sonrası örnek alınacaksa, genellikle birkaç gün beklenmesi önerilir. Ayrıca örnek, ishalin aktif döneminde alınmalıdır; belirtiler geriledikten sonra alınan örnekler tanısal değeri düşürebilir. Bu hazırlık süreci, gaita kültürünün güvenilirliğini doğrudan etkiler.
Gaita Kültürü Sonucu Ne Zaman Çıkar?
Gaita kültürü sonucu, bakterilerin laboratuvar ortamında üremesi için gereken süreye bağlı olarak genellikle 2–4 gün içinde sonuçlanır. Bu süre, hızlı testlere kıyasla daha uzun olsa da etkenin doğrudan saptanması açısından gereklidir.
İnkübasyon süresi boyunca dışkı örneğinde üreyen bakteriler değerlendirilir ve tanımlama işlemleri tamamlanır. Bazı durumlarda, üremenin yavaş olması veya ek doğrulama işlemleri gerekmesi nedeniyle sonuç süresi uzayabilir. Antibiyotik duyarlılık testleri yapılacaksa raporlama süresi birkaç gün daha uzayabilir. Bu nedenle gaita kültürü, hızlı sonuçtan ziyade kesin tanı gerektiren durumlarda tercih edilir.
Gaita Kültürü Sonucu Nasıl Yorumlanır?
Gaita kültürü sonucunun yorumlanması, dışkı örneğinde patojen bakteri üremesi olup olmamasına göre yapılır ve klinik bulgularla birlikte değerlendirilmelidir. Tek başına sonuç değil, hastanın şikâyetleri ve muayene bulguları da dikkate alınır.
Sonuç pozitif ise, dışkı örneğinde hastalığa neden olabilecek bir bakteri saptanmıştır ve etken mikroorganizma raporda belirtilir. Bu durum, hedefe yönelik tedavi planlanmasını sağlar. Sonuç negatif ise, örnekte kültürde üreyebilen patojen bakteri bulunmadığı anlamına gelir; ancak bu, ishalin mutlaka enfeksiyon dışı olduğu anlamına gelmez. Viral etkenler, parazitler veya kültürle saptanamayan bakteriler söz konusu olabilir. Bu nedenle gerekirse ek testlerle değerlendirme yapılır.
Gaita Kültürü ile Parazit İncelemesi ve PCR Yöntemleri Arasındaki Farklar
Gaita kültürü, yalnızca dışkı örneğinde üreyebilen bakterilerin saptanmasına yönelik bir yöntemdir; parazitler ve viral etkenler bu yöntemle gösterilemez. Bu nedenle her ishal vakasında tek başına yeterli olmayabilir ve klinik tabloya göre farklı yöntemlerle birlikte değerlendirilir.
Parazit incelemesi, bağırsak enfeksiyonlarına yol açan protozoon ve helmintleri mikroskobik olarak saptamayı hedeflerken; PCR yöntemleri bakteri, virüs veya parazitlerin genetik materyalini doğrudan tespit eder. PCR, hızlı ve duyarlı bir yöntem olmakla birlikte her merkezde rutin olarak uygulanmayabilir. Gaita kültürü ise canlı bakterinin üretilmesini sağladığı için etkenin doğrulanması ve gerektiğinde antibiyotik duyarlılığının belirlenmesi açısından klinik değer taşır.
Gaita Kültürü Fiyatı
Gaita kültürü fiyatı çalışılan bakteri paneline, laboratuvarın teknik altyapısına ve ek değerlendirmelerin yapılıp yapılmadığına göre değişiklik gösterebilir. Standart kültür işlemi ile birlikte antibiyotik duyarlılık çalışmaları yapılması, fiyatı etkileyen temel unsurlardan biridir.
Fiyat değerlendirilirken yalnızca maliyet değil, örnek kabul kriterleri, raporlama süresi ve mikrobiyolojik uzmanlık düzeyi de dikkate alınmalıdır. Uygun koşullarda çalışılmayan gaita kültürleri hatalı sonuçlara yol açabileceğinden, güvenilir laboratuvar tercihi tanısal doğruluk açısından kritik önem taşır.
Gaita Kültürü Nerede Yapılır?
Gaita kültürü, mikrobiyoloji altyapısı bulunan ve dışkı örneklerini uygun koşullarda kabul edebilen laboratuvarlarda yapılır. Testin güvenilirliği, yalnızca kullanılan cihazlara değil; örnek kabul, inkübasyon ve değerlendirme süreçlerinin uzmanlıkla yürütülmesine bağlıdır.
Gaita kültürü yapılacak laboratuvarda uygun besiyerleri, kontrollü inkübasyon koşulları ve mikrobiyoloji uzmanı değerlendirmesi bulunmalıdır. Ayrıca örneğin zamanında işlenmesi ve doğru raporlanması tanısal doğruluk açısından kritik öneme sahiptir. Bu nedenle gaita kültürü, rastgele değil; deneyimli ve teknik yeterliliği olan merkezlerde tercih edilmelidir.
Test için hemen arayın, size yardımcı olalım.